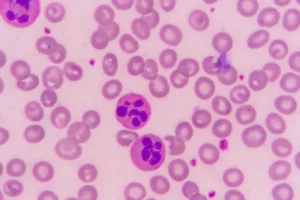

MDR Clinical Evaluation for Intimate Lubricant
IDMP Proof-of-Concept

Project Summary
A global top 5 pharmaceutical company was looking to evaluate an IDMP solution including core application functionalities, complexities involved in current data readiness, source systems and business processes for data collection and processing.
Celegence Solution & Approach:
The organization wanted to leverage the data in existing systems for IDMP compliance and maximize usage of the current functional systems through harmonized business processes. Celegence was awarded a contract to help the customer with the business process related activities, including process definition & evaluation of the following activities:
Highlights:
Data Gathering
Submission Management
End-to-End Operational Data Management
Definition and evaluation of business strategy based on PoC findings
Validation & Compliance Analysis from business process perspective
Project Achievements
Assessed readiness for IDMP compliance considering Iteration #1 data elements for end-to-end data management
Defined the end-to-end process for data management
Identified the right data source and extraction approach for Iteration #1 including data import (both one time and ongoing) from source systems like RIMS, Smpc, CCDS, etc.
Discussed Federated Data Governance approach and establishing Data Governance Committee
Reviewed IDMP data elements for Iteration #1 and concluded that most of these can be made available in the existing source systems
Conducted due-diligence and complex scenarios to be evaluated from each functional area point of view in the context of contributing to IDMP compliance & maintenance of reference data
The end-to-end approach taken by Celegence resulted in significant learnings and business process improvements across the organization.
Other Related Articles

29 Jun, 2026
Contact Us Today
From document publishing automation to eCTD submissions and beyond, Celegence is your trusted partner for regulatory affairs excellence. Contact us to learn how we can help you achieve your compliance goals efficiently and cost-effectively.
* indicates required fields